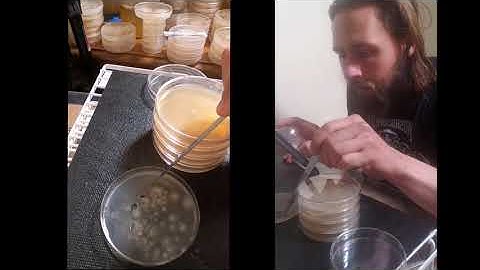
Mushroom Strain Isolation From a Multispore Inoculation

⬇ DOWNLOAD NOW
Kalau muncul iklan pop-up, tutup lalu klik tombol kembali
Download lagu Isolating Spores on Agar (Part 2) | Purifying an Isolate | Mushroom Cultivation secara gratis hanya untuk keperluan promosi. Dukung artis favorit kamu dengan membeli musik original di iTunes atau platform resmi lainnya.
 Isolating Spores on Agar (Part 1) | Germinating An Isolate From Spore | Mushroom Cultivation
Isolating Spores on Agar (Part 1) | Germinating An Isolate From Spore | Mushroom Cultivation
 Isolating Spores on Agar (Part 3) | Storing Cultures in Slants | Mushroom Cultivation
Isolating Spores on Agar (Part 3) | Storing Cultures in Slants | Mushroom Cultivation
 Spore Syringe to Agar - The Agar Files
Spore Syringe to Agar - The Agar Files
 Mycology Lab 101: Agar Work, Cloning, Spores & Sterile Culture Technique for Mushroom Cultivation
Mycology Lab 101: Agar Work, Cloning, Spores & Sterile Culture Technique for Mushroom Cultivation
 How to Save a Contaminated Mushroom Culture
How to Save a Contaminated Mushroom Culture
Mushroom Strain Isolation From a Multispore Inoculation
Mushroom Strain Isolation From a Multispore Inoculation
 Breeding Cordyceps fungi | Multi-Ascospore isolation
Breeding Cordyceps fungi | Multi-Ascospore isolation
 Eliminating Bacteria In Spore Syringes | When and How to Use Agar Plates | Mushroom Cultivation
Eliminating Bacteria In Spore Syringes | When and How to Use Agar Plates | Mushroom Cultivation